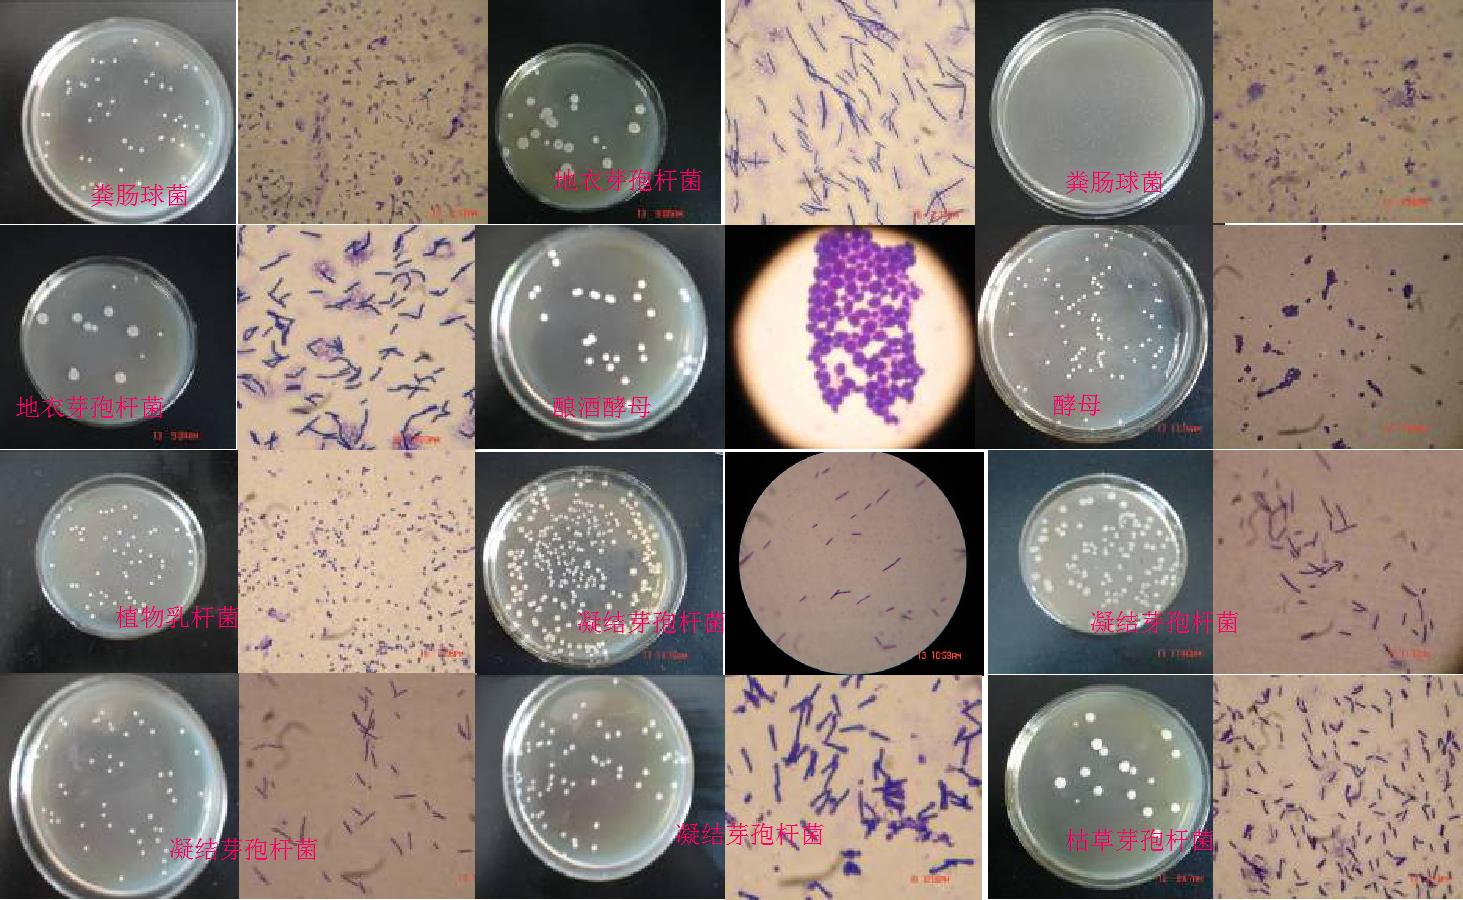
酵素发酵肥的使用方法,生物发酵肥制作

一、“酵素”概念祛魅
近些年在种植业中一种“生物酵素肥”的概念悄然升起,同时一些商家也推出了相应的产品,但是价格却高高在上,也让农户朋友们感觉“生物酵素”一定是一种高大上的科技产品。

今天我们先给“酵素”这个概念“祛魅”,去掉其神秘的光环。然后再给大家介绍制作生物酵素的原理,最后教给大家低成本批量制作生物酵素的方法。
“酵素”这一概念最初来源于日本,是“酶”这一词翻译过来的。有机质在微生物发酵之后,会产生大量的生物酶及其他代谢产物,这些代谢产物连同微生物在人体、动物体内、土壤中发挥着良性的作用,进而得到人们的关注。

酵素
酵素传入中国,最初兴盛于食品界,各种水果酵素成了中产们的最爱。后来渐渐应用到养殖业及种植业中,用来改善动物肠道、水体藻相菌相平衡、土壤碳氮比及土壤菌相平衡等。
在种植业中,酵素又称为“生物酵素肥”、“酵素菌肥”、“有机发酵碳肥”。如果按照制作原理及最终的产品组成,我们还可以将其归到“有机肥”或“液体有机肥”之中。所以,作为一名新农人,我们要看清一件事物背后的实质,不要被花里胡哨的概念所迷惑。
二、发酵原理
发酵的本质就是微生物繁殖!
生物酵素肥简单地说就是微生物发酵后的产物综合体,但是我们需要优化发酵所需要的温度、水分、氧气及物料等因素,以便于控制成本及最终发酵结果。
常见益生菌形态及菌落
例如在发酵过程中需要添加碳源,有人说加红糖、有人说加糖蜜,那白糖、葡萄糖等其他糖类是不是可以呢,下面我们详细探讨。
1、菌种的选择
选择合适的微生物菌种,我们在农业发酵工程中,一般选择的都是对人体、动植物有益的益生菌。而单一的菌种往往在繁殖的过程中会受到条件的抑制,造成发酵不彻底,所以需要多种益生菌协同发酵,以达到最佳状态。
在生物酵素肥的制作过程中,我们一般选择枯草芽孢杆菌、乳酸菌、酵母菌。它们在繁殖过程中各有各的特点,例如枯草芽孢杆菌是好氧菌,酵母菌是兼性厌氧菌,乳酸菌是厌氧菌。在发酵桶内发酵之初,枯草芽孢杆菌先利用环境中的氧气最先增殖的,等氧气浓度降低的时候酵母菌开始了快速增殖,因为酵母菌在有氧、无氧的环境下都能生存。

复合菌种协同发酵
等环境中的氧气全部耗尽的时候,乳酸菌开始快速增殖,同时乳酸菌代谢产生的乳酸造成环境Ph值降低,也进一步抑制了枯草芽孢杆菌、酵母菌及其他杂菌的繁殖。
2、碳源选择
益生菌在繁殖过程中不断利用环境中的碳源、氮源,以形成菌体的组织结构。我们发酵的基础物料都有其固定的碳氮比,例如果蔬、秸秆、麦麸等植物性物料,纤维素较高,所以碳氮比也相对较高。而畜禽粪便、屠宰下脚料等动物性物料,蛋白质较高,所以碳氮比相对较低。

物料碳氮比
益生菌在繁殖过程中要充分利用物料,就得把物料的碳氮比调整到合适的比例。例如我们在发酵畜禽粪便,制作有机肥的过程中,需要在粪便中加米糠、麦麸等物料,就是为了调整碳氮比。
我们在制作生物酵素肥的时候,为了让益生菌快速启动繁殖,需要对碳源进行优化,这就涉及到加什么糖的问题了。一般将糖类分为还原性糖和非还原性糖,还原性糖包括葡萄糖、果糖、乳糖等,它们大多可以直接被微生物所利用;非还原性糖包括蔗糖、淀粉、纤维素等,很多微生物不能直接利用它们,必须分解成还原性糖之后才能充分利用。

红糖
红糖主要成分都是蔗糖,但也包括少量单糖;白糖是红糖清洗、精制后的,所以蔗糖含量更高;糖蜜是甘蔗在制作红糖后的非结晶产物,含有较多的果糖及少量的蔗糖。所以这三种碳源相比糖蜜是最佳选择,并且糖蜜的价格也相比红糖低很多,并且方便采购。

糖蜜
当然,葡萄糖是相对理想的碳源,它是一种单糖,可被微生物直接吸收利用,如果价格能够控制在合理范围,也是可以考虑的。
3、物料选择
哪些物料可以制作生物酵素肥呢?一般而言,我们生活中的大多数农业有机质都可以作为发酵的物料,废弃的蔬菜瓜果、豆渣、菜籽饼、花生饼、米糠、麦麸、秸秆等等。我们自己制作生物酵素肥的原则就是就地取材、降低成本。

发酵物料
三、制作及使用方案
我们以残次水果蔬菜制作生物酵素为例:
1、物料处理,条件允许的情况下,我们要将果蔬进行打浆处理,没有条件的尽可能将果蔬切碎,以便使物料充分发酵。发酵物料3份。

果蔬物料
2、碳源选择,红糖或糖蜜1份。
3、水分控制,由于果蔬自身的水分含量较高,可以不添加水,制作成半干型酵素肥。也可添加9份的水,制作成液体型酵素肥。
4、菌种选择枯草芽孢杆菌、酵母菌、乳酸菌的复合菌,没有条件的可选用EM菌或其他发酵剂。

枯草芽孢杆菌
5、将以上物料混合后,放到清洁的发酵桶中,桶口用薄膜扎上,不要扎太紧,一方面防止外界杂菌进入,另一方面可让桶内代谢气体泄出。夏天3-5天左右即可发酵完成,春秋天在7-10天发酵完成。

发酵桶
6、使用的时候,半干型酵素肥可直接作为底肥施用。液体型酵素肥,下层沉淀发酵渣可作底肥施用;上层液体,50倍稀释后可浇灌地面,300倍稀释后可作叶面肥喷洒。
发酵工艺在农业上的应用范围很广,了解了发酵的基本原理,我们既可以制作发酵有机肥,也可以制作发酵饲料,发酵渔肥,进而控制种植业、养殖业的生产成本,提高经营效益。
关注【大乡】,一线新农人为您答疑解惑!